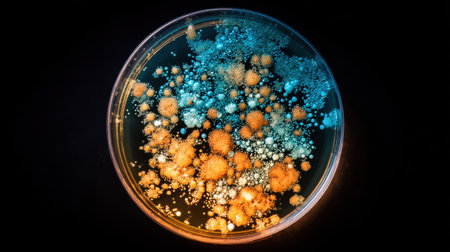
Microscopic bacteria in colony formation on agar plate viewed under bright lightの素材

素材 - Microscopic bacteria in colony formation on agar plate viewed under bright light
作品情報
Microscopic bacteria in colony formation on agar plate viewed under bright light
- ID:254215706
- 作品種別:
- 作者名:sawat burarat
キーワード
- analysis
- bacterium
- biological
- biology
- biotechnology
- cellular
- circular
- closeup
- colony
- creation
- crockery
- culture
- detail
- development
- disease
- exam
- experiment
- formation
- fungus
- germ
- growth
- health
- healthcare and medicine
- infection
- investigation
- isolate
- laboratory
- macro
- magnification
- medicine
- microbiology
- microscopic
- mobile phone
- no people
- observation
- organism
- pattern
- plate
- progress
- research
- science
- scientific
- study
- testing
- texture
- textured
- unhygienic
- yeast
類似作品
Surface contami...
Close-up of bac...
Visualization o...
Escherichia col...
Dynamic motion ...
Conceptual imag...
Threads of fung...
Colorful bacter...
Bacteria of dif...
Close up view r...
Macro close up ...
Helicobacter py...
Pills encircle ...
Enterobacterias...
Scientific imag...
Macro close up ...
Blue bacteria w...
Bacteria macro ...
Surface with ba...
Diverse colorfu...
Bacteria on a s...
High-res image ...
Bacterial colon...
Brightly colore...
A close up of a...
Explore the mes...
Mold Beautiful,...
Microscopic Vie...
Close-up of ger...
Colony characte...
Melon skin text...
Bacteria cells ...
3d illustration...
close-up of bac...
Digital illustr...
A close-up of b...
Microbes are se...
close up of mic...
Bacteria and vi...
Green bacteria ...
A detailed digi...
cyan colored ba...
A close-up view...
Helicobacter py...
Probiotics Bact...